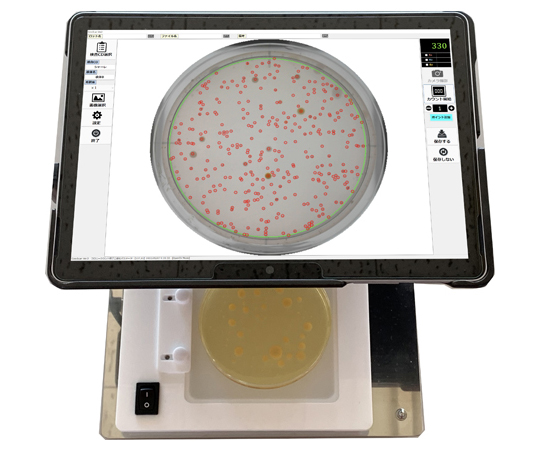
コロスキャン

|
商品番号
|
商品名・規格・入数 |
通常価格 |
販売価格
|
注文数 |
|
65-3366-29
|
-
 取寄せ
取寄せ
コロスキャン
11個
(11個あたり574,240円(税込10% 631,664円))
|
- メーカー希望小売価格
-
592,000円
(税込 651,200円)
|
-
-
574,240 円
(税込 631,664 円)
|
ご注文にはログインが必要です
|
|

3-8679-01
製品番号:CL-13
|
-
 取寄せ
取寄せ
コードレス乾燥器(AC・DC両用) CL-13
11個
(11個あたり34,960円(税込10% 38,456円))
|
- メーカー希望小売価格
-
38,000円
(税込 41,800円)
|
-
-
34,960 円
(税込 38,456 円)
|
ご注文にはログインが必要です
|
|

3-8679-02
製品番号:CL-17
|
-
 取寄せ
取寄せ
コードレス乾燥器(AC・DC両用) CL-17
11個
(11個あたり38,460円(税込10% 42,306円))
|
- メーカー希望小売価格
-
41,800円
(税込 45,980円)
|
-
-
38,460 円
(税込 42,306 円)
|
ご注文にはログインが必要です
|
|

2-4000-13
|
シランコートスライドグラス APS-01 1箱(100枚入)
11箱(100枚入り)
(11箱(100枚入り)あたり3,360円(税込10% 3,696円))
|
- メーカー希望小売価格
-
3,650円
(税込 4,015円)
|
-
-
3,360 円
(税込 3,696 円)
|
ご注文にはログインが必要です
|
|

2-4000-14
|
-
 取寄せ
取寄せ
シランコートスライドグラス APS-02 1箱(100枚入)
11箱(100枚入り)
(11箱(100枚入り)あたり3,360円(税込10% 3,696円))
|
- メーカー希望小売価格
-
3,650円
(税込 4,015円)
|
-
-
3,360 円
(税込 3,696 円)
|
ご注文にはログインが必要です
|
|

2-4000-15
|
シランコートスライドグラス APS-03 1箱(100枚入)
11箱(100枚入り)
(11箱(100枚入り)あたり3,360円(税込10% 3,696円))
|
- メーカー希望小売価格
-
3,650円
(税込 4,015円)
|
-
-
3,360 円
(税込 3,696 円)
|
ご注文にはログインが必要です
|
|

2-4000-16
|
-
 取寄せ
取寄せ
シランコートスライドグラス APS-04 1箱(100枚入)
11箱(100枚入り)
(11箱(100枚入り)あたり3,380円(税込10% 3,718円))
|
- メーカー希望小売価格
-
3,670円
(税込 4,037円)
|
-
-
3,380 円
(税込 3,718 円)
|
ご注文にはログインが必要です
|
|

2-4000-17
|
-
 取寄せ
取寄せ
シランコートスライドグラス APS-05 1箱(100枚入)
11箱(100枚入り)
(11箱(100枚入り)あたり3,380円(税込10% 3,718円))
|
- メーカー希望小売価格
-
3,670円
(税込 4,037円)
|
-
-
3,380 円
(税込 3,718 円)
|
ご注文にはログインが必要です
|
|

1-4178-01
製品番号:SGD-F
|
スライドグラスドライヤー ファン SGD-F
11台
(11台あたり25,760円(税込10% 28,336円))
|
- メーカー希望小売価格
-
28,000円
(税込 30,800円)
|
-
-
25,760 円
(税込 28,336 円)
|
ご注文にはログインが必要です
|
|

1-4178-02
製品番号:SGD-HF
|
スライドグラスドライヤー ファン+ヒーター SGD-HF
11台
(11台あたり72,680円(税込10% 79,948円))
|
- メーカー希望小売価格
-
79,000円
(税込 86,900円)
|
-
-
72,680 円
(税込 79,948 円)
|
ご注文にはログインが必要です
|
|

2-1041-01
製品番号:1枚用
|
スライドケース 100入 1枚用
11箱(100個入り)
(11箱(100個入り)あたり9,920円(税込10% 10,912円))
|
- メーカー希望小売価格
-
12,100円
(税込 13,310円)
|
-
-
9,920 円
(税込 10,912 円)
|
ご注文にはログインが必要です
|
|

2-1041-02
製品番号:2枚用
|
スライドケース 100入 2枚用
11箱(100個入り)
(11箱(100個入り)あたり14,920円(税込10% 16,412円))
|
- メーカー希望小売価格
-
18,200円
(税込 20,020円)
|
-
-
14,920 円
(税込 16,412 円)
|
ご注文にはログインが必要です
|
|

4-5866-01
製品番号:62301
|
スライドトレー 62301
11個
(11個あたり1,650円(税込10% 1,815円))
|
- メーカー希望小売価格
-
1,900円
(税込 2,090円)
|
-
-
1,650 円
(税込 1,815 円)
|
ご注文にはログインが必要です
|
|

4-5867-01
製品番号:62351
|
スライドファイル 62351
11個
(11個あたり2,260円(税込10% 2,486円))
|
- メーカー希望小売価格
-
2,600円
(税込 2,860円)
|
-
-
2,260 円
(税込 2,486 円)
|
ご注文にはログインが必要です
|
|

4-5865-01
製品番号:62211
|
スライドボックス 62211
11個
(11個あたり826円(税込10% 908円))
|
- メーカー希望小売価格
-
950円
(税込 1,045円)
|
-
-
826 円
(税込 908 円)
|
ご注文にはログインが必要です
|
|

4-5865-02
製品番号:62212
|
スライドボックス 62212
11個
(11個あたり1,220円(税込10% 1,342円))
|
- メーカー希望小売価格
-
1,400円
(税込 1,540円)
|
-
-
1,220 円
(税込 1,342 円)
|
ご注文にはログインが必要です
|
|

4-5865-03
製品番号:62213
|
スライドボックス 62213
11個
(11個あたり1,650円(税込10% 1,815円))
|
- メーカー希望小売価格
-
1,900円
(税込 2,090円)
|
-
-
1,650 円
(税込 1,815 円)
|
ご注文にはログインが必要です
|
|

2-4679-11
製品番号:12-587-17B
|
スライドメイラー 1箱(25個入) 12-587-17B
11箱(25個入り)
(11箱(25個入り)あたり4,140円(税込10% 4,554円))
|
- メーカー希望小売価格
-
4,500円
(税込 4,950円)
|
-
-
4,140 円
(税込 4,554 円)
|
ご注文にはログインが必要です
|
|

1-9651-13
製品番号:31011105MA
|
スライドメーラー 78×21×31mm 1箱(80個入) 31011105MA
11箱(80個入り)
(11箱(80個入り)あたり3,540円(税込10% 3,894円))
|
- メーカー希望小売価格
-
4,070円
(税込 4,477円)
|
-
-
3,540 円
(税込 3,894 円)
|
ご注文にはログインが必要です
|
|

1-9651-05
製品番号:31011005MA
|
スライドメーラー 82×30×17mm 1箱(100個入) 31011005MA
11箱(100個入り)
(11箱(100個入り)あたり4,650円(税込10% 5,115円))
|
- メーカー希望小売価格
-
5,350円
(税込 5,885円)
|
-
-
4,650 円
(税込 5,115 円)
|
ご注文にはログインが必要です
|